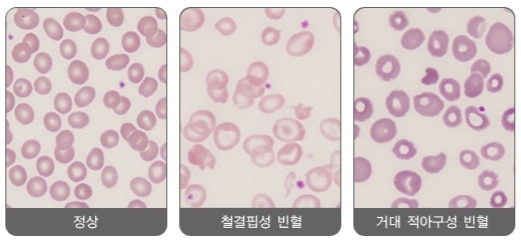
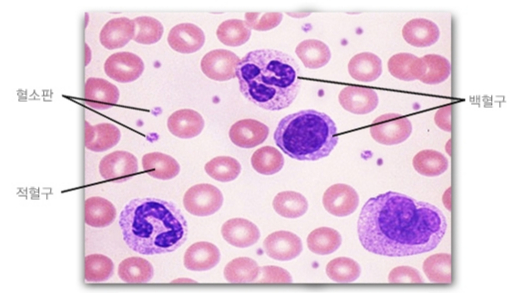
혈액 속 다양한 세포들. /사진=국가건강정보포털

[정심교의 내몸읽기]
국내에서 빈혈 환자가 늘고 있다. 질병관리청의 '2023년 국민건강통계'에 따르면, 10세 이상 빈혈 유병률은 2023년 기준 남성 3.3%, 여성 14.8%로 전년 대비 소폭 증가했다.
특히 '젊은 층'에서 성별 차이가 뚜렷하다. 19~29세에선 빈혈 환자가 남성의 0.2%에 불과했지만, 여성은 10%로 높았다. 30~39세 남성은 1.2%, 여성은 18.2%가 빈혈이었고, 40~49세 남성의 1.8%, 여성의 21.7%가 빈혈로 진단받았다. 젊은 연령대일수록 여성의 빈혈 유병률이 남성보다 월등히 높았다.
반면 70세 이상에선 남성 21.1%, 여성 20.2%로 거의 비슷해 고령층에서는 성별 격차가 줄어드는 양상을 보였다. 전반적으로 여성과 고령층을 중심으로 빈혈 유병률이 꾸준히 증가하고 있어 빈혈에 대한 관심과 관리가 필요한 것으로 나타났다.
빈혈은 우리 몸의 조직과 장기에 산소를 공급하는 적혈구 수 또는 헤모글로빈 농도가 정상보다 낮아진 상태다. 이에 따라 어지러움, 쇠약감, 두통, 가슴 통증, 창백한 피부, 팔다리 저림 등의 증상이 나타날 수 있다.

주요 원인으로는 철분 부족, 만성질환, 유전질환, 출혈 등이 있다. 특히 여성에서 빈혈이 많은 이유는 생리, 임신, 출산으로 인한 철분 손실과 체내 철분 요구량 증가 때문이다. 또한, 에스트로겐, 프로게스테론 등 여성호르몬이 혈액 생성과 철분 대사에 영향을 미치며, 극단적인 칼로리 제한이나 특정 영양소 결핍을 초래하는 편식성 다이어트로 철분 섭취가 부족할 경우 체내 철분 저장량이 충분히 확보되지 못해 빈혈이 발생할 수 있다.
이런 이유로 빈혈은 흔히 여성에게 주로 발생하는 질환으로 인식되지만, 성별과 상관없이 70세 이상에서 빈혈 유병률이 유독 높다. 특히 70세 이상은 남녀 빈혈 유병률이 거의 비슷해 만성질환이 많은 고령층에서도 빈혈이 흔히 동반될 수 있음을 보여준다.
빈혈 환자의 대표적인 만성질환으로는 만성 신부전, 류마티스 관절염, 크론병, 궤양성 대장염, 심부전, 만성 간 질환 등이 있으며, 이들 질환은 적혈구 생성이나 철분·비타민 대사에 영향을 줘 빈혈을 유발·악화할 수 있다.
대동병원 종합건강검진센터 김윤미 과장(가정의학과 전문의)은 "빈혈은 원인에 따라 일시적이거나 장기간 지속할 수 있으며, 증상도 경증에서 중증까지 다양해 나타나 단순 피로로 넘기기 쉽다"며 "빈혈은 단순히 적혈구가 부족한 상태일 뿐 아니라, 때로는 만성질환의 신호일 수 있다"고 설명했다.
특히 중증 빈혈은 적혈구 수치가 정상치로 회복하기까지 몇 주에서 몇 개월이 걸릴 수 있다. 중증 빈혈을 방치했다간 혈액 내 산소가 부족해져 부정맥 같은 다른 질환으로 이어질 수 있다. 김 과장은 "설명되지 않는 피로, 창백함 등의 증상이 지속되면 반드시 병원을 방문해 원인을 확인해야 한다"고 조언했다.
독자들의 PICK!
빈혈 진단은 환자 병력과 증상, 전체혈구계산(CBC)을 포함한 혈액 검사를 통해 이뤄지며, 원인에 따라 철분제, 엽산을 복용하거나 비타민 주사 치료를 시행한다. 만성질환으로 인한 빈혈은 해당 질환 치료에 초점을 맞춘다.
충분한 적혈구를 생산하기 위해서는 철분뿐만 아니라 단백질, 비타민 섭취도 중요하다. 육류·달걀·우유·생선·두부 등 철분·단백질이 풍부한 식품, 신선한 채소, 과일을 충분히 섭취하는 게 좋다.
청량음료·커피·차 종류는 철분 흡수를 방해할 수 있으므로 피하는 게 바람직하다. 규칙적인 운동, 충분한 수면을 통해 전반적인 신체 건강을 유지하는 것도 빈혈 예방에 도움 된다. 필요하면 주치의와 상담해 철분 보충제, 비타민제를 적절히 활용하는 것도 예방에 도움 된다.